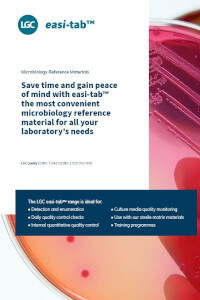

Catalogues & Publications
Food, Beverage and Environment Pharmaceutical Research Proficiency Testing Industrial Forensic NML
Latest Publications
PFAS Reference Material Portfolio to support EPA Method 1633
DownloadMikromol - Together, beyond the standard
Mikromol Reference Standards Catalogue
Food & Environmental Matrix Reference Materials Catalogue
DownloadLGC AXIO Proficiency Testing Catalogue
easi-tab™: Microbiology reference materials
DownloadNew Psychoactive Substances
DownloadConductivity certified reference materials
DownloadConsumables for sample preparation catalogue
DownloadCancer research catalogue
DownloadUCMR 5 Reference Material Portfolio
DownloadEU Drinking Water Directive
DownloadHow to read a COA for TRC Products
DownloadFood, Beverage and Environment
Residues of veterinary medicines in food – regulation & testing in the EU
Residues of veterinary medicinal products in food - outside of the EU
Use of stable isotope internal standards for trace organic analysis
Residues of pharmaceuticals in the environment
Reference standard for testing pesticides and pesticide metabolites
The importance of metabolites in trace organic residue analysis
Reference standards for testing residues of veterinary medicinal products
Comprehensive index of pesticides and associated metabolites
Dr. Ehrenstorfer Food Contact Materials (FCMs) 2019
Dr. Ehrenstorfer Food Contact Mindfulness
Discover Ehrenstorfer Quality
Smart Solutions v700 Pestimix Kit 2
Pesticide Analytical Testing: Why does it matter? How we can help
Mycotoxins: The hidden cannabis threats
Dr. Ehrenstorfer smart solutions made to measure
DownloadDr. Ehrenstorfer Catalogue of RMs for Food, Environmental and Cannabis Analysis
DownloadDr Ehrenstorfer EPA series methods 500 and 600
Dr. Ehrenstorfer food fraud
LGC Food Contact Chemical Infographic
DownloadSmart Solutions v400 GC Pestimix Kit1
Food & Environmental Matrix Reference Materials Catalogue
DownloadDr Ehrenstorfer Nitrosamine Reference Materials
New cannabinoid mixtures designed to optimise laboratory productivity
Marine and freshwater toxins reference materials
All your NMI produced reference materials from a single source
Dr Ehrenstorfer heritage infographic
DownloadSmart Solutions v59 PharmaVetResiMix kit
DownloadReference materials for cannabis testing
DownloadLGC InBio Elisa 2.0 - Quantitative food allergen detection
DownloadLGC InBio Purified food allergens - Natural and recombinant
DownloadSmart Solutions TerpiMix kit
DownloadSmart solutions iMix portfolio
Downloadeasi-tab™: Microbiology reference materials
DownloadPharmaceutical and veterinary medicines infographic
DownloadOur customers’ views on the revolutionary iMix Smart Solutions™
DownloadMycotoxin Reference & Research Materials
DownloadPerfluoroalkylated substances (PFAS) reference materials
UCMR 2017 Oct LGC Catalogue
High-quality reference materials for analysis of contaminants regulated by UCMR 5
DownloadUCMR 5 Reference Material Portfolio
DownloadEU Drinking Water Directive
DownloadPFAS Reference Material Portfolio to support EPA Method 1633
DownloadEPA method 8260 for the analysis of volatiles in solid waste & wastewater
EPA method 8270 for the analysis of semi-volatiles in solid waste & wastewater
Dr. Ehrenstorfer: What our Certificate of Analysis tells you
MEEP Gas Laboratory Control Standards
Global VOC standards to address a volatile global problem
Volatile organic compounds (VOCs)
Quality control standards for EPA method 1664 oil & grease
DownloadPharmaceutical
Cardiovascular APIs and impurities
Analgesic Active Pharmaceutical Ingredients (APIs) and impurities
Antidiabetic Active Pharmaceutical Ingredients (APIs) and impurities
Mikromol reference standards catalogue
EDQM reference standards available from LGC
Antiviral Active Pharmaceutical Ingredients (APIs) & Impurities catalogue
Antiinfective Pharmaceutical Ingredients (APIs) & impurities catalogue
API and impurity reference standards for ranitidine alternatives catalogue
LGC pharmaceutical outsourcing services
COVID-19 related API and impurity reference standards
Degradation reference materials 2021 - N-oxides
Excipient Reference Materials
Mikromol - Together, beyond the standard
Pharmacopoeial reference standards and their current lot numbers
DownloadPrimary pharmaceutical reference standards and reference material services
DownloadMikromol special offers
DownloadMikromol new products 2023
DownloadNitrosamine impurity reference standards
DownloadValsartan scientific poster
DownloadLGC Ibuprofen Synth Route poster
DownloadResearch
Isotope Labeled Compounds
Flame Retardants
USP Related Compounds
Water Contaminants
Proposition 65: The safe drinking water and toxic enforcement act
Cancer research: Therapeutic & research targets
DownloadNeurodegenerative diseases and mental disorders
DownloadNeurology catalogue
DownloadInfectious disease catalogue
DownloadInfectious disease research
DownloadCancer research catalogue
DownloadCancer research: Progress & challenges
DownloadTackling the Hidden Epidemic: Advances in Pain Management Drug Discovery
DownloadProficiency Testing
LGC AXIO Proficiency Testing Catalogue
PT Food Analysis: Prevention is better than cure
PORTAL user guide
DownloadFood & Feed Proficiency Testing Schemes
DownloadWater & Environment Proficiency Testing Schemes
DownloadConsumer Safety Proficiency Testing Schemes
DownloadBeverage Proficiency Testing Schemes
DownloadForensic Proficiency Testing Schemes
DownloadPetroleum Proficiency Testing Schemes
DownloadClinical Proficiency Testing Schemes
DownloadIndustrial
ColdBlock Digestion
ColdBlock Sample Digestion Technology
Fuel Analysis Reference Materials
Acid Number Certified Reference Materials
Base Number Certified Reference Materials
Biodiesel Standards
HK150 Sample Grinder
HK200 Disk Grinder
Jet A & Jet A-1 Aviation Turbine Fuel Analysis Standards
NIST High Performance ICP-OES Methodology
Polysulfide Oil Standards
V-SOLV ICP Solvent
Oil Condition Monitoring Reference Materials
Metals certified reference materials and calibration standards
Inorganic certified reference materials (CRMS) and calibration standards
General purpose viscosity standards
DownloadPhysical reference materials
DownloadPowder geological reference materials
DownloadNitrogen and Sulfur calibration sets and check standard ampoule kits
DownloadColour standards certified reference standards
DownloadConsumables for sample preparation catalogue
DownloadDriving the start of the green revolution creating vital reference materials for REE prospecting
DownloadConductivity certified reference materials
DownloadA Brand-New Era in Combatting The World's Energy Consumption
DownloadForensic
Forensic and clinical products and services
Antiepileptic reference materials
Antibiotic reference materials
Antiretroviral reference materials
Cardiac drug monitoring reference materials
Immunosuppressant reference materials
Vitamin D reference materials
Antifungal reference materials
Two independent sources reference materials
Drug and metabolite reference materials
Fentanyls reference materials
Biogenic Amine reference materials
LoGiCal: Reference materials for forensic analysis
LoGiCal: Narcotics in Synthetic Oral Fluid
LGC forensics sports doping brochure
Designer Fentanyls - Drugs that kill and how to detect them: Cyclopropyl-fentanyl
Designer Fentanyls - Drugs that kill and how to detect them: Methoxyacetyl- fentanyl
DownloadDesigner Fentanyls - Drugs that kill and how to detect them: Carfentanil
Ethanol and other related reference materials
DownloadNew Psychoactive Substances
DownloadLGC LoGiCal special offers: Forensic and clinical toxicology reference materials for drug and metabolite testing.
DownloadNML
NML reference material catalogue

.png)





_page_01.jpg)





%2band%2bimpurities_page_01.jpg)











































































